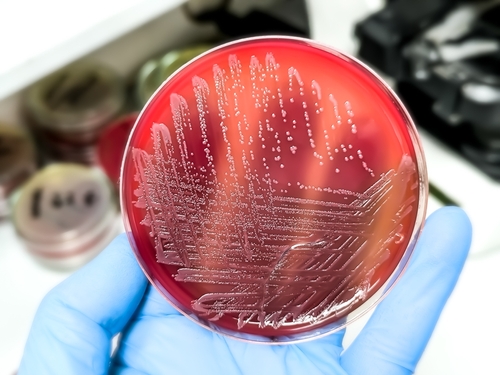
Bakteri Salmonella

Share This Article
Dari banyak jenis bakteri, Salmonella adalah salah satu yang harus diwaspadai. Bakteri yang mudah ditemukan di lingkungan sekitar itu bisa menyebabkan gangguan kesehatan. Efek bakteri Salmonella dapat terjadi dalam skala ringan hingga yang memerlukan bantuan medis.
Lantas, apa saja efek bakteri Salmonella yang bisa terjadi pada tubuh? Bagaimana cara mencegah penularannya? Yuk, simak ulasan lengkapnya berikut ini!
Baca juga: Wajib Tahu, Ini Gejala Tipes yang Tidak Boleh Kamu Sepelekan
Sekilas tentang Salmonella

Salmonella merupakan salah satu bakteri yang menjadi pemicu banyak kasus diare. Dikutip dari Medical News Today, ada lebih dari 2.500 jenis bakteri Salmonella, 100 di antaranya bisa menginfeksi tubuh manusia.
Di Amerika Serikat sendiri, menurut Centers for Disease Control and Prevention (CDC), dalam setahun, setidaknya ada satu juga kasus penyakit yang dipicu oleh infeksi bakteri tersebut. Makanan adalah sumber utama penularan bakteri Salmonella.
Penularan bakteri Salmonella
Bakteri Salmonella bisa hidup di tubuh beberapa hewan sebelum bermigrasi ke manusia. Kebanyakan kasus pada manusia terjadi setelah makanan atau air yang dikonsumsi telah terpapar oleh bakteri tersebut. Penularan bisa terjadi melalui:
- Daging mentah: Daging, produk laut, dan unggas yang tidak dimasak adalah penyebab paling umum penularan Salmonella. Tak hanya setelah dimakan, penularan bakteri bisa berlangsung meski kamu hanya menyentuh makanan mentah yang terkontaminasi.
- Telur kurang matang: Telur mentah atau yang dimasak setengah matang bisa memicu infeksi Salmonella pada manusia.
- Buah dan sayuran: Menyiram atau mencuci buah dan sayuran dengan air yang terkontaminasi bisa menyebabkan penularan bakteri.
- Faktor kebersihan: Saat tangan dan lingkungan sekitar seperti dapur jarang dibersihkan, risiko penularan infeksi Salmonella bisa meningkat.
- Hewan peliharaan: Reptil dan hewan lain dapat terkontaminasi Salmonella dalam perutnya tanpa menunjukkan gejala. Penularan bisa terjadi melalui kotorannya, lalu menyebar cepat ke kulit, furnitur, pakaian, dan permukaan benda lainnya.
Baca juga: Hindari Makan Daging Ayam Mentah, Ini Bahayanya!
Efek bakteri Salmonella pada tubuh manusia
Efek bakteri Salmonella biasanya muncul antara enam jam hingga beberapa hari setelah paparan pertama. Ada banyak gangguan kesehatan yang mungkin dapat dirasakan seseorang setelah terpapar bakteri tersebut, seperti:
1. Gejala umum
Orang yang terinfeksi Salmonella sering kali tak menyadari adanya bakteri tersebut di dalam tubuh. Efek bakteri Salmonella yang kerap muncul di awal waktu meliputi:
- Diare
- Demam mendadak
- Kram dan sakit perut
- Mual dan muntah.
2. Efek dehidrasi
Saat diare akibat infeksi Salmonella berlangsung cukup lama, kamu bisa mengalami kekurangan cairan. Sebab, diare membuatmu lebih sering buang air besar, sehingga banyak cairan yang ikut dikeluarkan.
Maka dari itu, untuk meminimalkan risiko tersebut, ada baiknya kamu langsung memperbanyak minum air begitu mengalami diare. Dikutip dari Mayo Clinic, dehidrasi akibat diare biasanya ditandai dengan:
- Penurunan urine
- Mulut dan lidah menjadi kering
- Mata cekung
- Penurunan produksi air mata.
2. Efek bakteri Salmonella pada darah
Efek bakteri Salmonella berikutnya adalah bakteremia, yaitu kondisi ketika aliran darah sudah terpapar dan terkontaminasi. Bakteri kemudian dapat menginfeksi banyak jaringan, seperti sumsum tulang belakang, otak, lapisan jantung dan katupnya, serta dinding pembuluh darah.
Beberapa kasus bakteremia tidak menunjukkan gejala awal, karena sistem kekebalan bisa melakukan perlawanan tanpa kamu sadari. Namun, ketika sistem imun tak mampu mengatasinya, terutama jika jumlah bakteri sudah terlalu banyak, gejala yang mungkin muncul adalah:
- Demam
- Panas dingin
- Gemetar atau menggigil.
3. Efek bakteri Salmonella pada sendi
Orang yang pernah terinfeksi Salmonella memiliki risiko lebih tinggi terkena radang sendi atau arthritis. Bukan sekadar radang sendi, melainkan arthritis reaktif atau yang dikenal dengan sindrom Reiter. Efek bakteri Salmonella yang dapat muncul meliputi:
- Iritasi pada mata
- Nyeri saat buang air kecil
- Rasa sakit pada area persendian.
4. Penyakit tipes
Tifus atau yang biasa disebut tipes merupakan salah satu penyakit yang diakibatkan oleh Salmonella typhi. Gejala paling umum dari penyakit ini adalah demam tinggi yang berlangsung berhari-hari.
Pada banyak kasus, seseorang yang mengidap tipes harus menjalani rawat inap di rumah sakit. Selain agar cepat sembuh, hal tersebut untuk meminimalkan komplikasi.
Menurut sebuah publikasi di Perpustakaan Kedokteran Nasional Amerika Serikat, tipes dapat memicu komplikasi yang membahayakan nyawa. Di tingkat global, penyakit ini sudah menyebabkan 100 ribu kematian setiap tahunnya.
Baca juga: Jangan Anggap Sepele, Ini 7 Gejala Tipes pada Anak yang Harus Diwaspadai!
Bagaimana cara mencegah penularan?
Dari berbagai efek bakteri Salmonella di atas, penting untuk melakukan langkah pencegahan agar tak terpapar. Kamu bisa meminimalkan risiko penyebaran bakteri dengan cara:
- Cuci tangan dengan sabun setiap sebelum dan sesudah menyantap makanan, menggunakan kamar mandi, menyentuh hewan peliharaan, berkebun, serta mengganti popok bayi
- Pisahkan makanan mentah dan matang
- Simpan makanan mentah di kulkas
- Cuci buah dan sayur menggunakan air bersih sebelum dimakan
- Hindari konsumsi makanan mentah atau setengah matang, terutama daging dan telur
- Jaga kebersihan dapur dan peralatan masak
- Hindari minum air yang tidak melalui proses pengolahan, seperti dari sungai dan danau
- Simpan telur pada suhu di bawah 4° Celcius, segera buang jika retak atau kotor
- Jangan biarkan hewan peliharaan, terutama reptil dan amfibi, untuk tinggal di dalam rumah
- Jika ada seseorang di dalam rumah yang terinfeksi, cuci pakaian, seprai, dan handuk dengan air panas.
Baca juga: Indonesia Juga Tarik Produk Kinder Diduga Mengandung Salmonella, Bakteri Apa Itu?
Nah, itulah beberapa efek bakteri Salmonella pada kesehatan dan cara penularan yang perlu kamu tahu. Agar tak tertular dan terinfeksi, lakukan langkah-langkah pencegahan seperti yang telah disebutkan, ya!
Konsultasikan masalah kesehatan kamu dan keluarga melalui Good Doctor dalam layanan 24/7. Mitra dokter kami siap memberi solusi. Yuk, download aplikasi Good Doctor di sini!